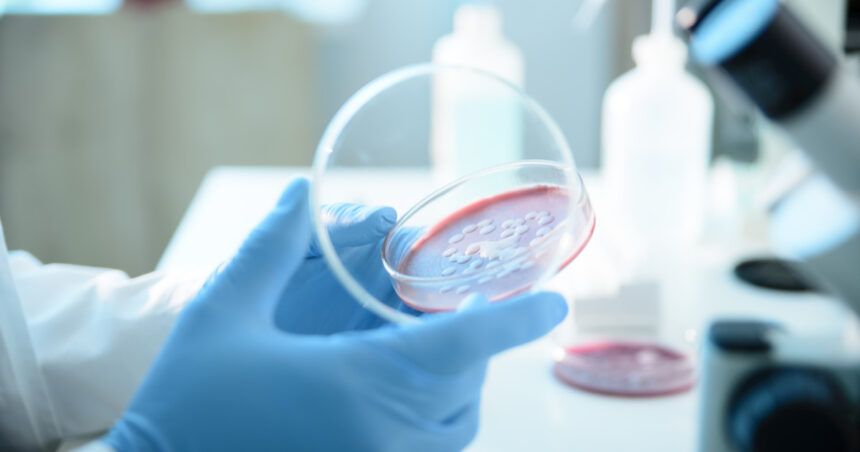

Bacteria Serratia marcescens și impactul său la Spitalul „Sfânta Maria” din Iași
Serratia marcescens este o bacterie omniprezentă în mediul înconjurător, inclusiv în apă, sol și pe suprafețe umede, care poate provoca infecții severe la oameni. Aceasta este întâlnită frecvent în spitale, în special în secțiile de terapie intensivă, unde pacienții sunt supuși unor proceduri invazive, precum intubațiile și utilizarea cateterelor, facilitând astfel pătrunderea bacteriei în organism.
Direcția de Sănătate Publică (DSP) Iași a demarat o anchetă epidemiologică la Spitalul de Copii „Sfânta Maria” în urma decesului a șase copii în secția de Terapie Intensivă, suspectându-se un posibil focar de infecții cauzate de această bacterie.
Riscurile asociate cu Serratia marcescens
Serratia marcescens poate provoca o gamă variată de infecții, inclusiv infecții ale tractului respirator (pneumonie), infecții ale tractului urinar, infecții oculare, infecții ale rănilor, infecții abdominale (peritonită), meningită și septicemie. Persoanele cel mai expuse riscului sunt cele cu boli cronice, sistem imunitar compromis sau vârstnici, care pot dezvolta complicații severe, inclusiv sepsis.
Transmiterea și simptomele infecției
Transmisia bacteriei se realizează prin contact direct cu o persoană infectată sau prin suprafețe și echipamente medicale contaminate. Simptomele infecției depind de localizarea acesteia și pot include febră, frisoane, letargie, dificultăți de respirație, dureri la nivelul ochilor, dureri la urinare și dureri de cap.
Este esențial ca diagnosticarea infecției să fie realizată prin analize de laborator, iar tratamentul poate fi complicat din cauza rezistenței bacteriei la antibiotice, ceea ce îngreunează recuperarea pacienților afectați.
Ce este Serratia marcescens?
Serratia marcescens este o bacterie care poate dezvolta rezistență la unele antibiotice. Medicul poate solicita analiza unei probe pentru a identifica antibioticul cel mai eficient în tratamentul infecției. În anumite cazuri, este necesară utilizarea unei combinații de medicamente pentru a combate infecția.
Contextul de la Spitalul „Sfânta Maria” din Iași
Potrivit Ministerului Sănătății, din datele medicale disponibile la momentul actual, nu se poate stabili o legătură directă între infecțiile asociate asistenței medicale, celelalte patologii, comorbiditățile pacienților și deces. Legătura de cauzalitate dintre infecția cu Serratia marcescens și decesul copiilor va fi evaluată de experții în medicină legală.